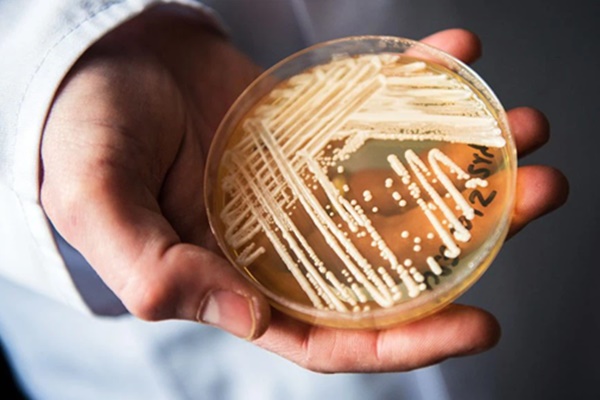
Bình Dương ghi nhận thêm 23 ca mắc Covid-19 mới, trong đó có 22 ca từ ổ dịch ở thị xã Tân Uyên-2

Trong đó có 22 ca liên quan đến ổ dịch phường Tân Phước Khánh, TX. Tân Uyên (17 ca liên quan đến công ty tại phường Bình Chuẩn, TP. Thuận An; 05 ca liên quan đến chuỗi lây nhiễm ở chi nhánh Xử lý chất thải) và 01 ca tại phường Bình Nhâm, TP. Thuận An liên quan chợ đầu mối Hóc Môn, TP.HCM. Tất cả trường hợp trên đều ngoài khu công nghiệp.
Cụ thể về địa chỉ cư trú, có 12 ca tại phường Bình Chuẩn, TP. Thuận An; 02 ca phường An Phú, TP. Thuận An; 01 ca ở phường Bình Nhâm, TP. Thuận An; 05 ca phường Hiệp An, TP. Thủ Dầu Một; 01 ca phường Bình Tân, TP. Dĩ An; 01 ca phường Khánh Bình, TX.Tân Uyên và 01 ca phường Tân Vĩnh Hiệp, TX. Tân Uyên.
Tính đến thời điểm hiện tại, liên quan đến ổ dịch phường Tân Phước Khánh, TX. Tân Uyên đã có tổng cộng 140 ca mắc.

Tính từ đợt dịch thứ 4, tỉnh Bình Dương ghi nhận 164 ca mắc Covid-19 trong cộng đồng
Liên quan đến ổ dịch tại phường Bình Nhâm, TP. Thuận An, phát hiện thêm 01 tiểu thương (là F1 của BN13349 đã được công bố ngày 21/6) cũng có địa chỉ tại phường Bình Nhâm, TP.Thuận An buôn bán tại chợ đầu mối Hóc Môn, TP.HCM mắc Covid-19.
Lũy kế ổ dịch này có 03 trường hợp mắc. Trước đó, ngày 19/6/2021, BN13349 (địa chỉ tại phường Bình Nhâm, TP.Thuận An) buôn bán ở chợ đầu mối Hóc Môn, TP. HCM có triệu chứng sốt, ho, mệt mỏi được con gái đưa đi khám bệnh; qua test nhanh và PCR kết quả cả 2 mẹ con dương tính SARS-CoV-2.
Ngành Y tế đã truy vết khoảng 3.000 trường hợp F1, gần 8.000 trường hợp F2. Xét nghiệm sàng lọc cộng đồng gần 9.149 người tại phường Tân Phước Khánh, 4.088 người tại công ty có địa chỉ phường Bình Chuẩn, TP. Thuận An (ngoài khu công nghiệp), khu nhà trọ và nhiều khu vực khác liên quan; 2.500 người tại khu vực xung quanh công ty đóng tại phường Bình Hòa, TP. Thuận An (ngoài khu công nghiệp).
Lũy kế đã có 40.911 trường hợp được lấy mẫu xét nghiệm SARS-CoV-2. Số lượng mẫu xét nghiệm tích lũy là 36.411 mẫu.
Tính từ đợt dịch thứ 4, tỉnh Bình Dương ghi nhận 164 ca mắc Covid-19 trong cộng đồng.
Hiện tại Bệnh viện Đa khoa tỉnh đang điều trị cho 166 bệnh nhận (164 bệnh nhân lây nhiễm cộng đồng, 01 ca tái dương tính từ Khánh Hòa, 01 chuyên gia nhập cảnh), các bệnh nhân có tình trạng sức khỏe ổn định. Trong số các bệnh nhân này có 01 bệnh nhân lớn tuổi (sinh năm 1948) và 03 bệnh nhân dưới 5 tuổi.
Theo Doanh nghiệp và Tiếp thị